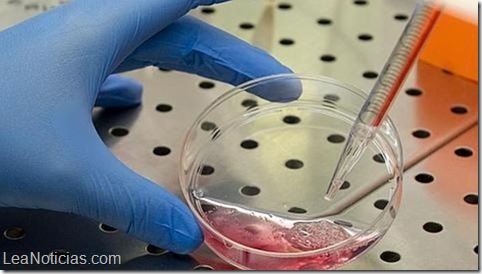

¿Qué hace que algunas personas sean resistentes de forma natural al VIH? Según un estudio de la Universidad de Minnesota (EE.UU.), que ha analizado las variaciones genéticas del virus que causa el sida, existe una grieta en la coraza del virus que podría explicar en parte por qué algunos individuos enferman rápidamente mientras otros permanecen inmunes. Los resultados abren la puerta nuevos tratamientos.
Tal y como se explica en el artículo que se publica en «Plos Genetics» el VIH infecta al invadir la las células del sistema inmunitario conocidas como linfocitos T, impidiendo su reproducción y destruyendo así las células huésped. De esta forma el sistema inmune queda muy debilitado, lo que hace que la persona infectada sea más susceptible a otras enfermedades mortales.
Se sabe que entre los mecanismos de defensa de los linfocitos T hay una clase de proteínas, APOBEC3s, que son capaces de bloquear la capacidad de replicación del VIH. Sin embargo, el virus tiene un mecanismo de lucha contra esa defensa, una proteína llamada Vif que pelea contra los linfocitos T destruyendo su propio APOBEC3.
Pieza clave
Debido a que los investigadores han sospechado que la diferencia en la susceptibilidad al VIH podría estar relacionada con variaciones genéticas en este sistema, el equipo de investigación dirigido por Eric Refsland y Reuben Harris, ha analizado más en profundidad este mecanismo. En primer lugar, los investigadores vieron que la infección por VIH-1 estimula la producción de un tipo de APOBEC3, APOBEC3H, lo que sugiere que es una pieza clave en contraatacar. A continuación, utilizando una técnica experimental conocida como separación de la función de mutagénesis, descubrieron que diferentes personas tienen distintos puntos fuertes/potencias de APOBEC3H, con algunas proteínas expresadas de forma estable y otras inherentemente inestables.
Así los científicos han visto que las variaciones estables lograron limitar con éxito la capacidad del VIH de replicarse si éste tenía una versión débil de Vif, pero no para los virus con Vif fuerte. «Este trabajo muestra que la competencia entre el virus y el huésped está aún en desarrollo -dice Refsland-. Creemos que el virus no ha perfeccionado completamente su capacidad para replicarse en humanos».
Harris señala que el siguiente paso es encontrar la manera de detener la capacidad de Vif de desactivar las enzimas APOBEC3. «Este enfoque podría suprimir indefinidamente la replicación del virus e, incluso, lograr curarlo», concluye el experto.
Fuente [Abc.es]
